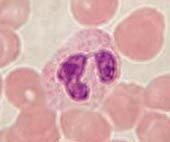

يهتم علم المناعة بدراسة كل الآليات التي تمكن الجسم من الحفاظ على تماميته أي تمييز كل ما هو ذاتي و الحفاظ عليه و غير الذاتي للتخلص منه.
/ عناصر الغير الذاتي:I
- الجراثيم : البكتيريات ، الحمات، الفطريات و الحيوانات الأولية .
- الأعضاء و الأنسجة الأجنبية عن الجسم.
- خلايا الجسم الشاذة : الخلايا المسنة أو السرطانية
/ تمييز الجسم بين ما هو ذاتي و غير ذاتي II
1- معطيات سريرية:
تعرض شخص لحروق بليغة تطلب زرع الجلد في مكان الإصابة على الشكل التالي:
نسبة النجاح
أصل الجلد
رفض تام للتطعيم صديق تقبل نسبي الأب تقبل تام الشخص نفسه
2- خلاصة:
يتبين أن العامل المحدد للذاتي هو الجينوم، و بما أن الجينوم يتكون من مورثات تتحكم في تركيب بروتينات، فان الأبحاث أدت إلى اكتشاف بروتينات توجد على الغشاء السيتوبلاسمي للخلايا المنواة تتدخل في تحديد ما هو ذاتي ( واسمات الذاتي) و سميت نظام HLA(Human Leucocyte Antigen) لأنها اكتشفت أول مرة فوق غشاء الكريات البيضاء ، و تمت ملاحظتها أيضا فوق غشاء الخلايا المنواة و سميت بذلك المركب الرئيسي للتلاؤم النسيجي CMH( Complexe Majeur d’Histocompatibilité)
3 – تركيب بروتينات CMH
يتحكم في تركيب بروتينات CMH أربع مورثات محمولة على الصبغي 6 وهي المورثات A ,C,B,D و تتميز بالخاصيات التالية:
-هي مورثات مرتبطة أي محمولة على نفس الصبغي
-متعددة الحليلات أي لكل مورثة عدة حليلات
المورثة A لها تقريبا 25 حليل
المورثة C لها تقريبا 10 حليلات
المورثة B لها تقريبا 50 حليل
المورثة D لها تقريبا 30 حليل
-الحليلات متساوية السيادية
سؤال : احسب عدد التوافقات الممكنة لبروتينات CMH لشخص معين . ماذا تستنتج؟
4 ـ أصناف بروتينات CMH
يوجد صنفين رئيسيين من بروتينات CMH هما :
ـ بروتينات CMHI : توجد على سطح خلايا الجسم المنواة باستثناء الخلايا الجنسية و الجنينية و الكريات الحمراء و يتحكم في تركيب هذا النوع المورثات A ، C و B . و تتكون هذه البروتينات من سلسلتين بيبتيديتين α و β2m .
ـ بروتينات CMHII : توجد على سطح بعض الخلايا المناعتية كاللمفاويات و البلعميات و تتحكم في تركيبها المورثة D و تتكون هذه البروتينات من سلسلتين بيبتيديتين α و β .
5 ـ دور بروتينات CMH :
في جميع الخلايا تجزئ أنزيمات خاصة عينة من البروتينات الموجودة في السيتوبلاسم إلى بيبتيدات ، يرتبط كل بيبتيد بجزيئة CMH و يهاجر المركب بيبتيد ـ CMH إلى سطح الخلية ، و هكذا تعرض الخلايا باستمرار محتواها البيبتيدي مما يمكن من حراسة مناعتية :
ـ إذا كانت البيبتيدات المعروضة منحدرة من بروتينات عادية للخلية فانه لا يحدث ارتباط بين الخلية و الخلايا المناعتية و بالتالي غياب الاستجابة المناعتية.انظر الوثيقة
ـ إذا كانت البيبتيدات المعروضة منحدرة من بروتينات غير عادية للخلية(بروتين شاذ لخلية سرطانية أو بروتين فيروسي) فانه يحدث ارتباط بين الخلية و الخلايا المناعتية و بالتالي حدوث الاستجابة المناعتية.انظر الوثيقة
وهكذا يتبين أن مركب CMH هو مجموع المورثات المسئولة عن تركيب بروتينات CMH المسئولة عن تحديد الذاتي ، ففي حالة زرع الأعضاء إذا كان CMH المعطي يخالف CMH المتلقي تحدث استجابة مناعتية مسئولة عن رفض الطعم لذلك تسمى بروتينات CMH مولدات مضاد التلاؤم النسيجي.
وسائل دفاع الجسم
I/المناعة غيرالنوعية أو الطبيعية:
1ـ الحواجز الطبيعية للجسم:
تحافظ هذه الحواجز على تمامية الجسم حيث تحول دون تسرب العناصر الأجنبية و تصنف حسب طريقة عملها إلى :
ـ الحواجز الميكانيكية : تتضمن الجلد الذي يتكون من خلايا متماسكة تتجدد باستمرار و غير منفذة للمتعضيات المجهرية و الأغشية المخاطية التي تحتوي على مخاط سطحي يحول دون تثبيت الجراثيم كما يمكن أن تتواجد أهذاب تتحرك باستمرار و تدفع بالجراثيم نحو الخارج.
ـ الحواجز البيوكيميائية : يحتوي المخاط الأنفي و اللعاب و الدموع على أنزيمات خاصة ( ليزوزومات) تتلف غشاء البكتيريات، العرق ذو ph حمضي يحول دون نمو الفطريات و بعض البكتيريات، تفرز المعدة حمض معدي يسبب موت الجراثيم، في الاثنا عشري يؤدي التغير المفاجئ لـ ph و الأنزيمات المحللة للبروتينات إلى منع التكاثر البكتيري.
ـ الحواجز الايكولوجية: الفلورة البكتيرية المعوية و الجلدية تحول دون تكاثر البكتيريات الممرضة و دلك عن طريق التنافس.
في بعض الحالات يمكن أن تخترق هذه الحواجز من طرف الجراثيم ليحدث رد فعل يتجلى في الاستجابة المناعتية الغير نوعية .
2 ـ الاستجابة المناعتية الغير نوعية:
2ـ1ـ الاستجابة الالتهابية:
أ ـ رد فعل الجسم على اثر غزو جرثومي:
يؤدي حدوث جرح على مستوى الجلد إلى استجابة دفاعية محلية تتميز بظهور الالتهاب الذي يتميز بالأعراض التالية:
الاحمرار و الانتفاخ و الألم و الارتفاع المحلي لدرجة الحرارة. انظر الوثيقة
ـ الانتفاخ نتيجة خروج البلازما لتسهيل انسلال الكريات البيضاء نحو مكان الجرح.
ـ الاحمرار و الارتفاع المحلي لدرجة الحرارة نتيجة تمدد الشعيرات الدموية و ارتفاع الصبيب الدموي في مكان الجرح.
ـ الألم نتيجة تهييج النهايات العصبية بواسطة الوسائط الالتهابية أو المواد المفرزة من طرف الجراثيم.
ب ـ الوسائط الالتهابية:
ـ الهيستامين : مادة تفرزها الخلايا البدينة (العمادية) تسبب تمدد الشعيرات الدموية و رفع نفاذيتها.
ـ البروستاغلاندين : مادة تفرزها الخلايا البدينة (العمادية) تسبب تمدد الشعيرات الدموية و رفع نفاذيتها.
ـ الكينين : هي عديدات بيبتيد تفرز أساسا من طرف الصفائح الدموية ، تنتج عن انشطار بروتين بلازمي تحت تأثير أنزيم يكون خاملا و يتم تنشيطه بواسطة مواد المضاد أو عامل التجلط ، تسبب تمدد الشعيرات الدموية و رفع نفاذيتها.
ـ عوامل التكملة : هي مركب أنزيمي يتكون من عدة بروتينات بلازمية يرمز لها بـ C1 ، C2 ، C3 ..... إلى C9 يتم تركيبها من طرف عدة أنسجة : الكبد ، الطحال ، الأمعاء ، البلعميات . و تكون غير نشيطة و يتم تنشيطها بطريقتين :
ـ طريقة تعاقبية : يتم التنشيط تلقائيا بواسطة مولد المضاد خلال المناعة النوعية,
ـ طريقة كلاسيكية : يتم التنشيط بعد ارتباط مولد المضاد مع مضاد الأجسام المقابل له خلال الاستجابة النوعية .
و تتجلى أدواره في:
ـ تسهيل انسلال الكريات البيضاء و انجذابها نحو موقع الخمج(الانجذاب الكيميائي) تدخل C3a و C5a انظر الوثيقة
ـ تشكيل مركب الهجوم الغشائي وذلك عن طريق تنشيط أنزيمي متتالي لعناصر عامل التكملة لترتبط بالغشاء الخلوي لمولد المضاد مشكلة قنوات تسمح بدخول الماء و الأملاح المعدنية إلى مولد المضاد و بالتالي انفجاره انظر الوثيقة
ـ تسهيل البلعمة بعد تثبيت عوامل التكملة C3b على مولد المضاد يتم تسهيل تثبيتها على غشاء البلعميات التي تتوفر على مستقبلات لعامل التكملة .انظر الوثيقة
2ـ2ـ البلعمة :
البلعمة هي عملية ابتلاع مولد المضاد من طرف خلايا تسمى البلعميات و تمثل المرحلة الأساسية في الاستجابة الغير نوعية .انظر الوثيقة1 ، الوثيقة 2
. و تتم عبر المراحل التالية:
ـ مرحلة التثبيت : ارتباط مولد المضاد بمستقبلات غشائية للبلعمية
ـ مرحلة الابتلاع : ترسل البلعمية أرجلا كاذبة تحيط بمولد المضاد و تلتحم ليصبح محبوسا داخل فجوة بلعمية
ـ مرحلة الهضم : تفرغ الليزوزومات محتواها الأنزيمي داخل الفجوة البلعمية لهضم مولد المضاد
ـ مرحلة إخراج الحطام : تطرح بقايا مولد المضاد خارج البلعمية
تتميز هذه الظاهرة بكونها فورية لأنها تنفذ مباشرة بواسطة البلعميات و غير نوعية لأنها موجهة ضد جميع مولدات المضاد .انظر الوثيقة
تؤدي البلعمة غالبا إلى انحلال مولد المضاد لكن يمكن أن يكون هناك عجز أنزيمي أو بكتيرية مقاومة فتحدث الحالات التالية :
ـ بقاء البكتيرية سليمة مدة من الزمن . انظر الوثيقة
ـ تكاثر مولد المضاد مما يؤدي إلى تدمير البلعمية و انتشار الخمج. انظر الوثيقة
2ـ3ـ أنواع الكريات البيضاء المتدخلة في المناعة الغير النوعية:
ـ الخلايا البدينة : تنتشر في مختلف الأنسجة و تحرر وسائط التهابية
ـ المحببات أو مفصصات النواة : و أهمها العدلات تتدخل في البلعمة كما أن هناك الحمضات و القعدات وهي تفرز وسائط التهابية .
ـ الوحيدات : تغادر باستمرار الدورة الدموية لتستقر بالأنسجة و تتحول إلى بلعميات كبيرة .
خلية بدينة تحتوي على حبيبات بها وسائط التهابية
خلية بدينة تحتوي على حبيبات بها وسائط التهابية
خلية بدينة تفرغ حبيباتها
عدلات
بلعمية كبيرة
وحيدة
حمضة
بلعمية كبيرة
وحيدة
قعدة
محببة
2ـ4ـ خلاصة :
II/المناعة النوعية :
من أجل التصدي لمولدات المضاد بصفة نوعية يتبع جهاز المناعة استراتيجيتين مختلفتين :
ـ انتاج مضادات أجسام نوعية ضد مولد المضاد نتكلم عن استجابة مناعتية خلطية أو ذات وسيط خلطي .
ـ انتاج كريات لمفاوية قاتلة نوعية قادرة تقضي على مولد المضاد نتكلم عن استجابة مناعتية خلوية أو ذات وسيط خلوي.
1ـ الجهاز اللمفاوي :
1ـ1ـ الأعضاء اللمفاوية :
1ـ2ـ الكريات اللمفاوية :
كرية لمفاوية
1ـ3ـ العقدة اللمفاوية :
2ـ نضج الكريات اللمفاوية :
1ـ1ـ اللمفاويات B :
يتم إنتاج و نضج الكريات اللمفاوية B على مستوى النخاع العظمي و تنتقل عبر الدم و اللمف إلى المراكز المحيطية التي تعتبر مراكز عبور و تراكم و تكاثر للكريات اللمفاوية .
أ ـ بنية الكريات اللمفاوية B :
ب ـ اكتساب الكفاية المناعتية :
تخضع الكريات اللمفاوية B لتربية على مستوى النخاع العظمي بحيث تتعلم التعرف على الذاتي و تمييزه عن ما هو غير ذاتي بواسطة مستقبلاتها الغشائية(مضادات الأجسام) حيث :
ـ يتم الحفاظ بالكريات اللمفاوية الحاملة لمستقبلات لا ترتبط ببيبتيدات الذاتي .
ـ حذف اللمفاويات الحاملة لمستقبلات ترتبط ببيبتيدات الذاتي .
بذلك تصبح اللمفاويات B ذات كفاية مناعتية قادرة على تحمل الذاتي .
1ـ2ـ اللمفاويات T :
يتم إنتاج الكريات اللمفاوية T على مستوى النخاع العظمي و تنتقل إلى الغدة السعترية ليتم نضجها .
أ ـ بنية الكريات اللمفاوية T :
ب ـ اكتساب الكفاية المناعتية :
الانتقاء الأول : على مستوى المنطقة القشرية للغدة السعترية حيث يحتفظ باللمفاويات T التي لها مستقبلات T لها ألفة مع CMH الذاتي و تحذف اللمفاويات الأخرى .
الانتقاء الثاني : على مستوى المنطقة النخاعية للغدة السعترية حيث تحذف اللمفاويات T التي لها مستقبلات T قادرة على الارتباط مع بيبتيدات الذاتي .
بذلك تصبح اللمفاويات T ذات كفاية مناعتية قادرة على تحمل الذاتي .
تحمل اللمفاويات T بالإضافة للمستقبلات T مؤشرات نوعية CD4 أو CD8 :
ـ إذا تم عرض بيبتيدات الذاتي بواسطة CMHI فان اللمفاوية T لا تركب إلا جزيئات CD8 و تصبح لمفاويات T8 .
ـ إذا تم عرض بيبتيدات الذاتي بواسطة CMHII فان اللمفاوية T لا تركب إلا جزيئات CD4 و تصبح لمفاويات T4 .
3ـ الاستجابة المناعتية ذات وسيط خلوي :
3ـ1ـ طور الحث :
ج ـ تكون T4 ذاكرة :
3ـ3ـ طور التنفيذ :
تسليط Tc القاتلة على الخلية الهدف (خلية معفنة أو خلية سرطانية أو خلية زرع) و بالتالي انحلالها.
4ـ الاستجابة المناعتية ذات وسيط خلطي :
4ـ1ـ طور الحث :
أ ـ الانتقاء اللمي :
انتقاء اللمفاويات B و T4 النوعية لمولد المضاد .
اللمفاويات B قادرة على التعرف المباشر على مولد المضاد بواسطة مضادات الأجسام الغشائية.
ب ـ التكاثر اللمي لـ T4 :
| ||||
| ||||
4ـ2ـ طور التضخيم :
أ ـ التكاثر اللمي للمفاويات B :
ب ـ التفريق اللمي للمفاويات B:
4ـ3ـ طور التنفيذ :
إنتاج مضادات الأجسام من طرف البلزميات لإبطال مفعول مولد المضاد و تشكل المركب المنيع .المركب المنيع
5ـ3ـ بنية و تنوع مضادات الأجسام:
أ ـ بنية مضادات الأجسام :
مضادات الأجسام هي بروتينات تنتمي إلى مجموعة الكريونات لذا تسمى الكريونات المناعتية ، رغم تنوعها فهي مكونة حسب نفس النموذج من سلسلتين ثقيلتين H و سلسلتين خفيفتين L
ب ـ أصناف مضادات الأجسام :
توجد 5 أصناف من مضادات الأجسام:
IgD IgE IgM IgA IgG اللمفاويات B
الخلايا البدينة و القعدات اللمفاويات B و الدم
المخاطات و إفرازاتها الدم التموضع أقل من 1%
أقل من 1%
10% 15% إلى 20% من مضادات الأجسام المصلية
70% إلى 75%
النسبة تنشيط اللمفاويات B
الأرجية و إبطال الطفيليات إحداث اللكد، و الطريقة الكلاسيكية لعامل التكملة إحداث اللكد،
إبطال البكتيريات و الحمات
إبطال السمينات و البكتيريات و الحمات الأدوار

0 التعليقات:
إرسال تعليق